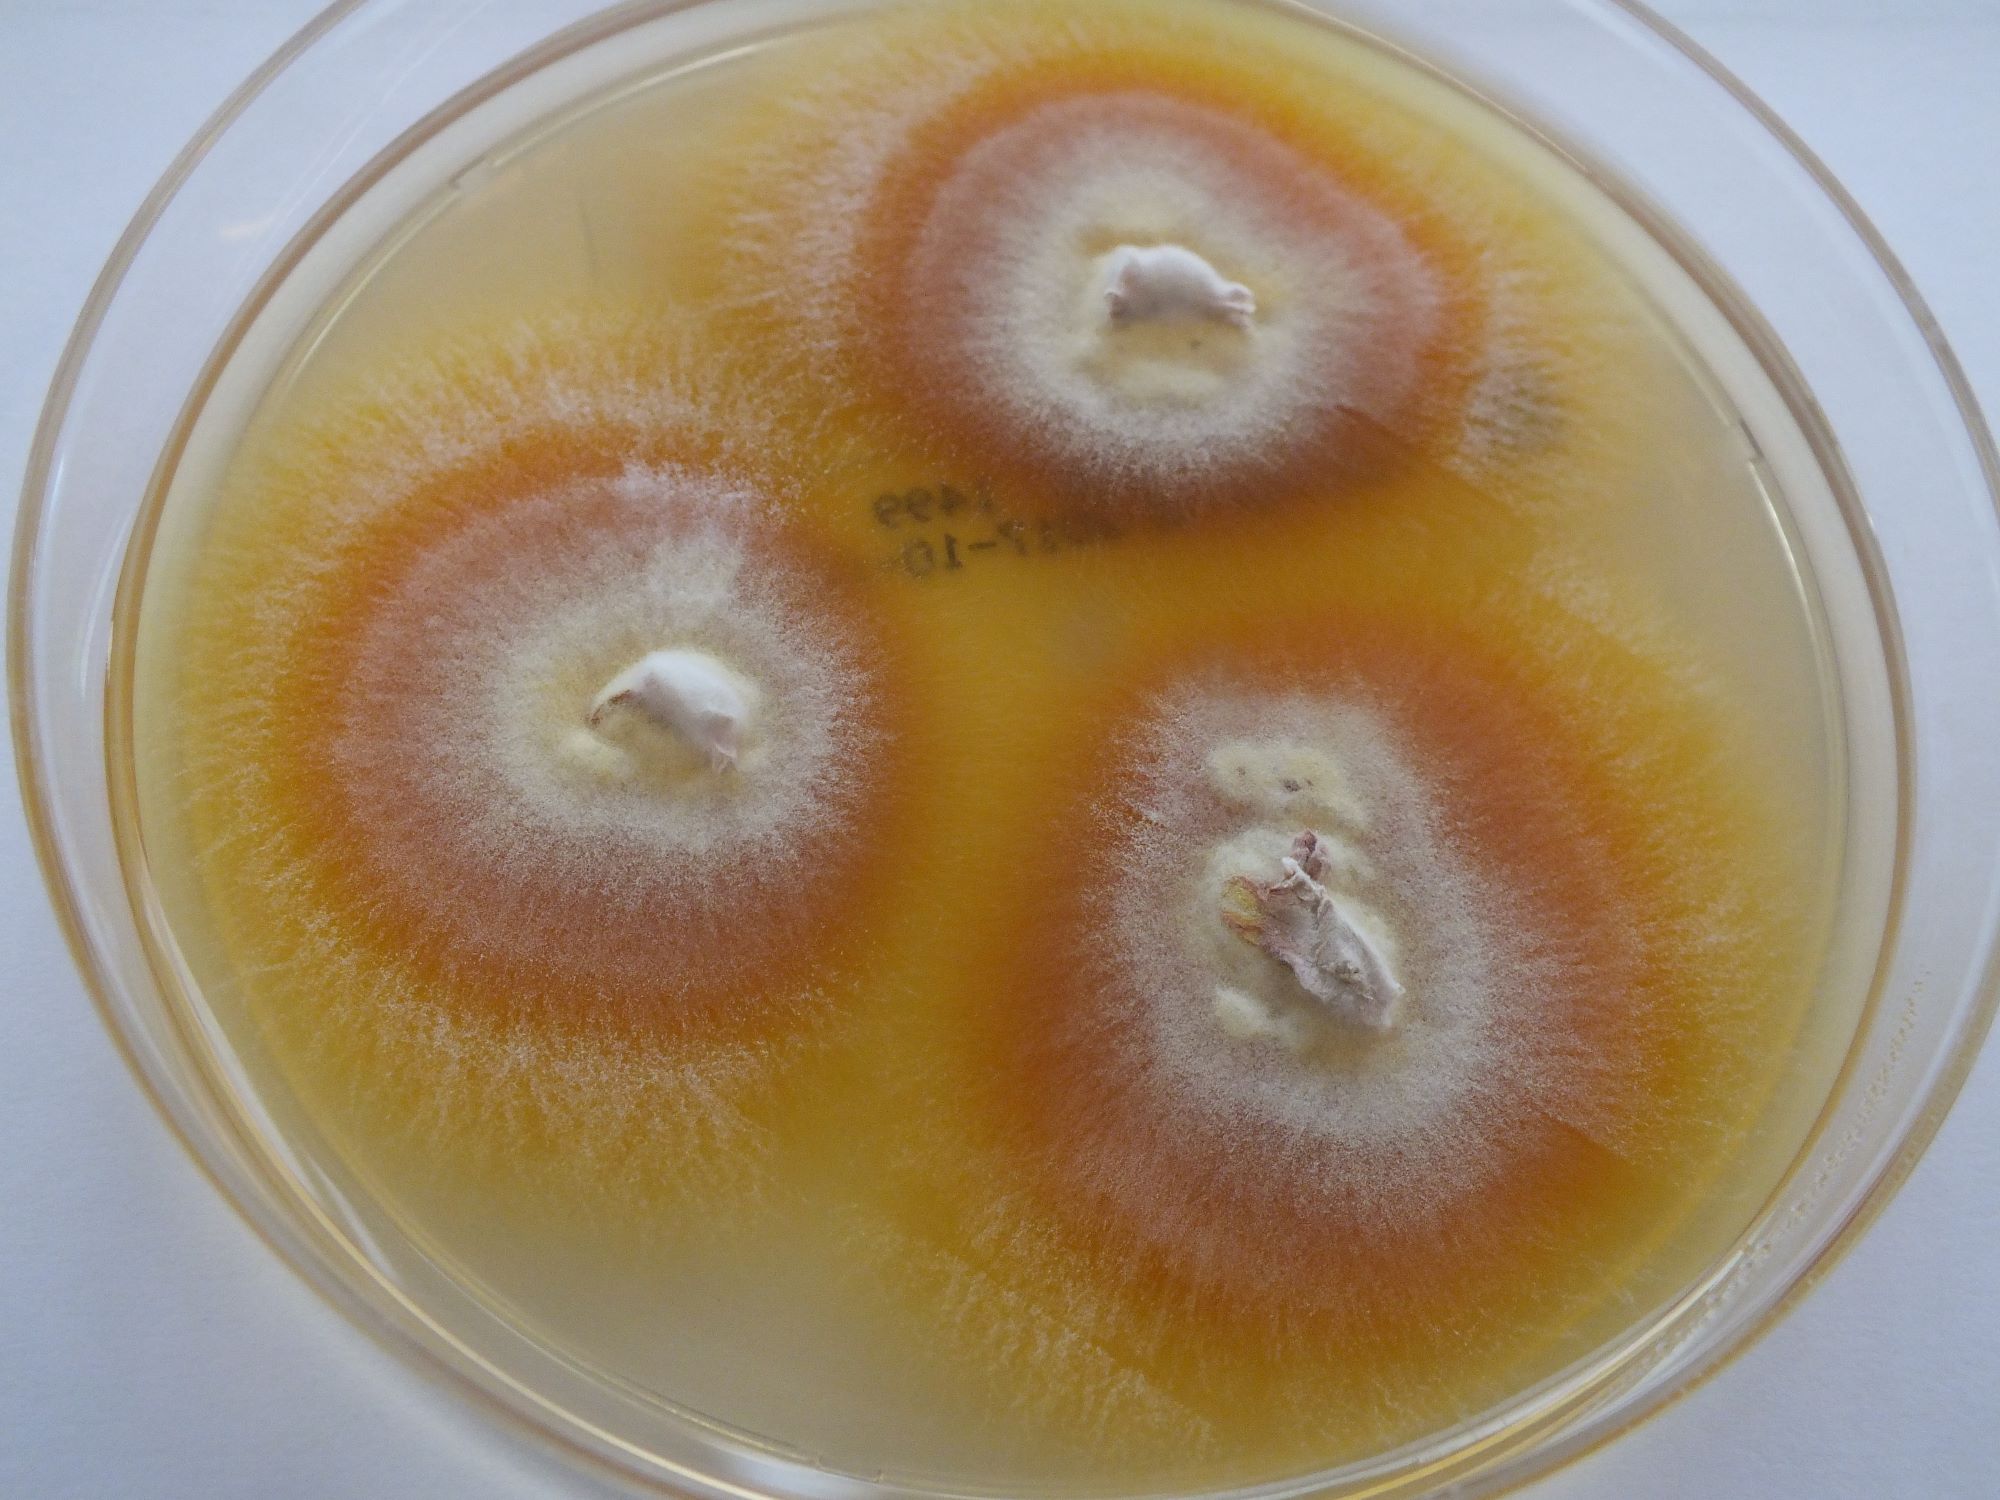
LABOPART Trichophyton equinum

Trichophton violaceum est une espèce de champignons de la famille des Arthrodermataceae.
C’est un des champignons responsables de la teigne.
Notes et références
Liens externes
- (en) Index Fungorum : Trichophyton violaceum Sabour., 1902 (consulté le )
- (en) MycoBank : Trichophyton violaceum Sabour., 1902 (consulté le )
- Portail de la mycologie